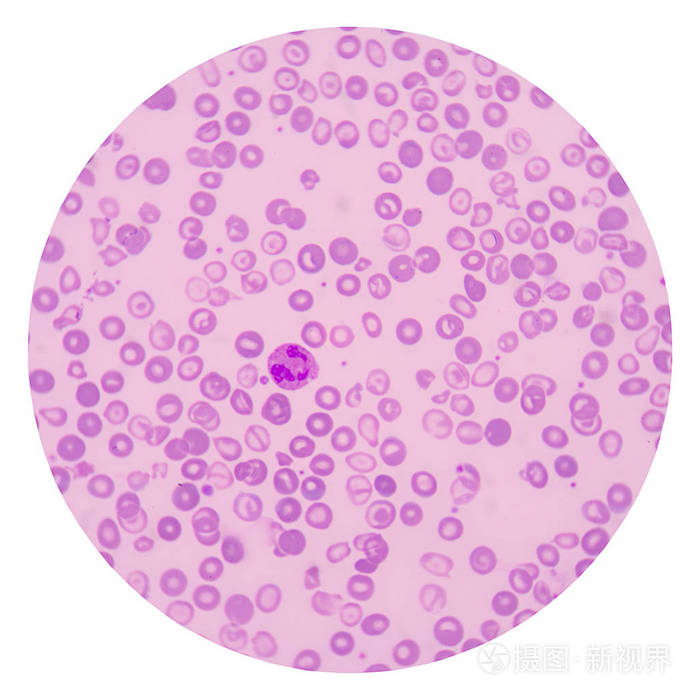
红血细胞白色背景医疗科学
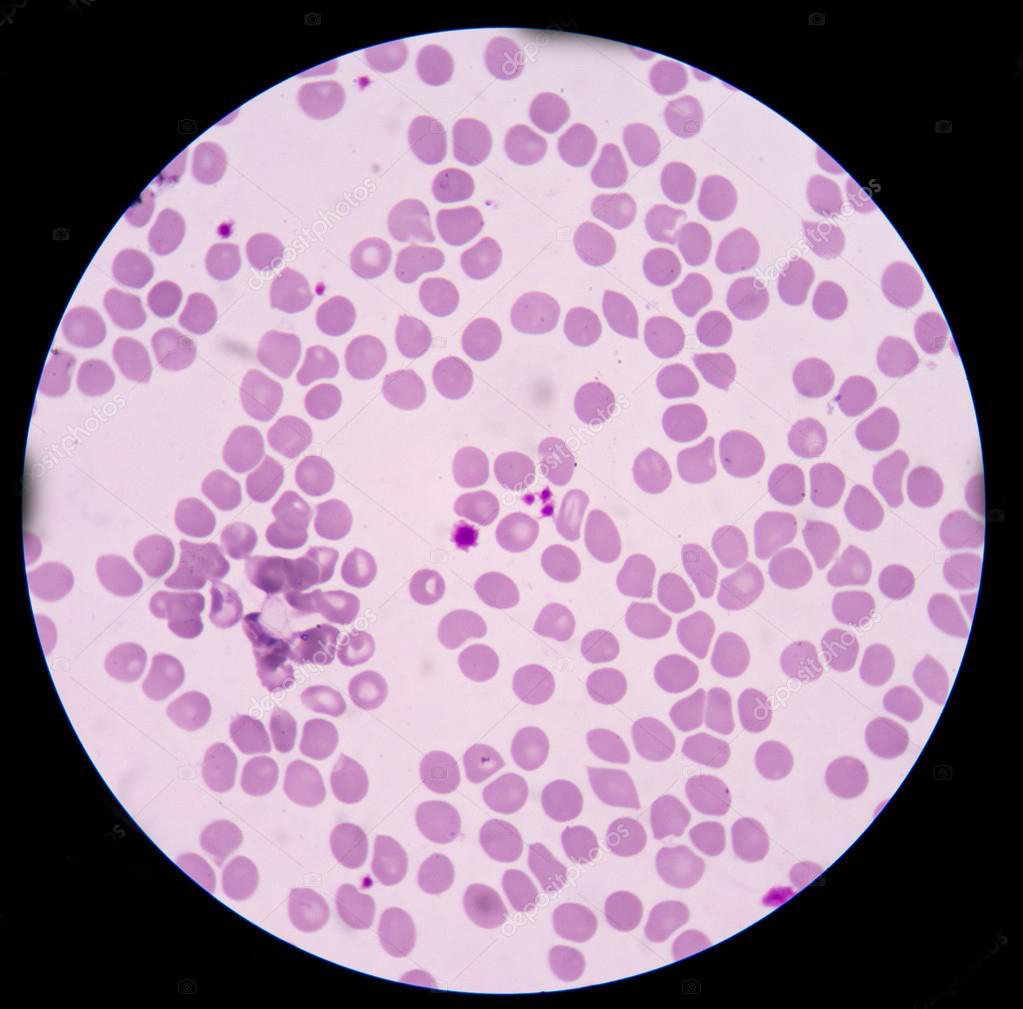
这种血细胞与癌症发生相关为何晚期肿瘤病人会异常升高

血细胞图片

白细胞 红细胞 人的血细胞彩图 血小板
图片尺寸1080x810
血细胞_插画_血_红血球_白细胞_图片大全—全景创意图库(quanjing.
图片尺寸794x529医疗血液细胞.
图片尺寸1100x1100
生物3d渲染效果红色血细胞
图片尺寸1280x960
七个血细胞样本,差别真大.人血细胞两种细胞很明显,其他是一种 - 抖音
图片尺寸1440x1832
图363血细胞
图片尺寸880x1182
红血细胞白色背景医疗科学
图片尺寸700x700
血细胞
图片尺寸550x440
血细胞可分为红细胞,白细胞和血小板.
图片尺寸5760x3162
图为正常红细胞
图片尺寸1000x750
红细胞图片
图片尺寸1280x960红细胞,血细胞,大规模的放大,形状,微生物学
图片尺寸1100x1100
制作血细胞~~东康中学初一465班张珈铭生物项目式学习作业
图片尺寸650x866
红细胞图片
图片尺寸1280x853
正常红细胞(图片来源网络)
图片尺寸600x600血细胞
图片尺寸791x1200
请你比较三种血细胞
图片尺寸1080x810
血细胞
图片尺寸670x447
红血细胞显微镜在医学背景概念下
图片尺寸700x688
这种血细胞与癌症发生相关为何晚期肿瘤病人会异常升高
图片尺寸1023x1009
猜你喜欢:各种血细胞的形状图片血细胞图片 示意图血细胞图片 成熟血细胞显微镜下的图片血细胞结构图血细胞图片 手绘图正常的血细胞图片淋巴细胞图片口腔上皮细胞图片血小板显微镜下图片白细胞形态白细胞吞噬细菌红细胞图片白细胞图片显微镜血细胞显微镜血细胞结构图手绘血液图片血液学细胞形态图片神经细胞图片单核细胞图片血细胞形态血涂片细胞形态图片血液涂片各种血细胞白细胞分类血细胞手绘图显微镜下的细胞血细胞分类图显微镜下白细胞图片血细胞示意图血细胞形态分析图片吕玲绮壁纸戒指手绘效果图食品表格图片大全丝路漫画2020最流行指甲图片VIVOy83诗情画意素描丛林式盆景的原则足球绘本图片醉鹅图片大全一笑奈何图片2020烫发发型图片男